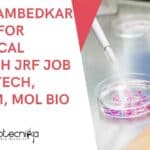
Dr. B.R. Ambedkar Center for Biomedical Research JRF Job For Biotech, Biochem, Mol Bio ACBR Delhi JRF Job

Home Search
microbiology - search results
If you're not happy with the results, please do another search
Freshers Biotech Job at Biotecnika, Bangalore For BDE Post | Apply Online
Freshers BDE Job Biotecnika
BioTecNika Info Labs Pvt Ltd runs India’s Largest Biosciences Career & education and learning Site and is currently looking to hire...
Biotecnika Times Newsletter 03.02.2023 Govt National Institute of Biologicals High Pay Jobs, IGIB Hiring
Biotecnika Times Newsletter 03.02.2023 Govt National Institute of Biologicals High Pay Jobs, IGIB Hiring
Govt National Institute of Biologicals Job With Rs. 75,000 pm Pay...
MSc/MTech Candidates With 0-2 Years Exp Apply For JRF/PA Job at TERI
TERI Freshers Job MSc, MTech Biotech, Genetics, Microbiology Apply
TERI Freshers Job MSc, MTech Biotech, Genetics, Microbiology Apply. Interested and eligible candidates with MSc, MTech...
Biotecnika Times Newsletter 02.02.2023 BARC OCES-2023 and DGFS-2023 Notification
Biotecnika Times Newsletter 02.02.2023 BARC OCES-2023 and DGFS-2023 Notification
BARC OCES-2023 and DGFS-2023 Notification - DAE-Training Schools Scientific Officers Recruitment 2023
BARC OCES-2023 and DGFS-2023 Notification...
Complete List Of PhD Scholarships / Fellowships Available in India For Life Sciences
PhD Fellowship & Scholarship in India
Ph.D. scholarships and fellowships in life sciences are a crucial aspect of research and education in India. They provide...
Dr. B.R. Ambedkar Center for Biomedical Research JRF Job For Biotech, Biochem, Mol Bio
ACBR Delhi JRF Job For Biotech, Biochem, Mol Bio, Microbiology
ACBR Delhi JRF Job For Biotech, Biochem, Mol Bio, Microbiology. Dr. B.R. Ambedkar Center for...
University of Delhi JRF Job For MSc, BTech Biotech, Biochem – Email Your Applications
University of Delhi JRF Job For MSc, BTech Biotech, Biochem - Email Your Applications
University of Delhi JRF Job For MSc, BTech Biotech, Biochem -...
ICMR-NIN JRF Leading to PhD Opportunity For Mol Bio, Genetics, Biotech & Biochem Candidates
NIN JRF to PhD For Mol Bio, Genetics, Biotech & Biochem Candidates
NIN JRF to PhD For Mol Bio, Genetics, Biotech & Biochem Candidates. MSc...
BARC OCES-2023 and DGFS-2023 Notification – DAE-Training Schools Scientific Officers Recruitment 2023
BARC OCES-2023 and DGFS-2023 Notification - DAE-Training Schools Scientific Officers Recruitment 2023
BARC OCES-2023 and DGFS-2023 Notification - DAE-Training Schools Scientific Officers Recruitment 2023. BARC...
Biotecnika Times Newsletter 01.02.2023 UPSC IFS Exam 2023 Notification, IMTECH, ICMR Hiring
Biotecnika Times Newsletter 01.02.2023 UPSC IFS Exam 2023 Notification, IMTECH, ICMR Hiring
UPSC IFS Exam 2023 - Indian Forest Service Exam 2023 Application, Eligibility
The application...
Important Announcement: Bioinformatics Global Tools & Techniques 21 Days Exclusive Hands-on Internship Postponed
Important Announcement: Bioinformatics Global Tools & Techniques 21 Days Exclusive Hands-on Internship Postponed
Bioinformatics Global Tools & Techniques 21 Days Exclusive Hands-on Internship
Hello Dear Biotecnikans
Due...
Biotecnika Times Newsletter 31.01.2023 DBT-RA Programme, TIFR Summer Research With Stipend
Biotecnika Times Newsletter 31.01.2023 DBT-RA Programme, TIFR Summer Research With Stipend
DBT-Research Associateship Programme in Biotech & Life Sciences 2022-2023 (Call-II)
DBT RA Programme 2022-2023 -...
Govt CDSCO MSc, PhD, BTech & MTech Biotech, Mol Bio, Biochem Job With Pay...
Govt CDSCO Research Jobs For MSc, PhD, BTech & MTech Biotech, Mol Bio, Biochem Job With Pay Upto Rs. 84,000 pm
Govt CDSCO Research Jobs...
CSIR-CFTRI BTech & MSc Research Fellow Recruitment, Online Application Process
CFTRI BTech Biotech JRF, MSc Biochem, Mol Bio & Microbiology Apply
CFTRI BTech Biotech JRF, MSc Biochem, Mol Bio & Microbiology Apply. CSIR-CFTRI Job Opening....
CSIR NET Exam 2023 Preparation Checklist For Getting Top JRF & LS Rank
CSIR NET 2023 Preparation Tips & Checklist for Life science exam
The Council of Scientific and Industrial Research (CSIR) National Eligibility Test (NET) is a...